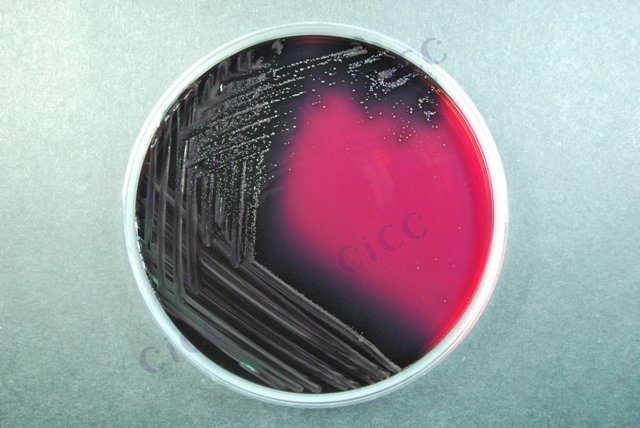
斯氏李斯特氏菌 Listeria seeligeri CICC 21671 Listeria seeligeri

斯氏李斯特氏菌 Listeria seeligeri CICC 21671 Listeria seeligeri
-
斯氏李斯特氏菌定量菌株 Listeria seeligeri
BNCC392856 | 西林瓶
-
斯氏李斯特氏菌定量菌株 Listeria seeligeri
BNCC393304 | 西林瓶
-
斯氏李斯特氏菌定量菌株 Listeria seeligeri
BNCC393307 | 西林瓶
-
伊氏李斯特氏菌伊氏亚种 Listeria ivanovii subsp. ivanovii Seeliger et al.
BNCC365315 | 冻干粉;斜面;菌液;平板
-
伊氏李斯特氏菌 Listeria ivanovii CICC 21663 Listeria ivanovii
CICC 21663 | 见证书
-
无害李斯特氏菌(英诺克李斯特氏菌) Listeria innocua CICC 10297 Listeria innocua
CICC 10297 | 见证书
-
无害李斯特氏菌(英诺克李斯特氏菌) Listeria innocua CICC 10416 Listeria innocua
CICC 10416 | 见证书

说明书下载: 菌种说明书 打管说明书
您正在浏览的产品:斯氏李斯特氏菌 Listeria seeligeri CICC 21671
手机版:斯氏李斯特氏菌 Listeria seeligeri CICC 21671
本公司销售的所有产品仅供实验科研使用,不用于人体及临床诊断。
2. 分离培养:PALCAM琼脂和显色培养基划线分离;
3. 鉴定:革兰氏染色、生化试验(木糖/鼠李糖发酵)、溶血试验及动力观察。
第三法(MPN法):适用于低浓度样本(<100 CFU/g)。
2. 分离培养基的菌落形态学观察;
3. 动力试验(25℃与37℃对比)及CAMP试验验证。
2. 第三法需结合统计学MPN表进行结果计算;
3. 溶血试验需使用马血琼脂平板,观察β-溶血环。
以上信息仅供参考,请以相应标准的原文为准!